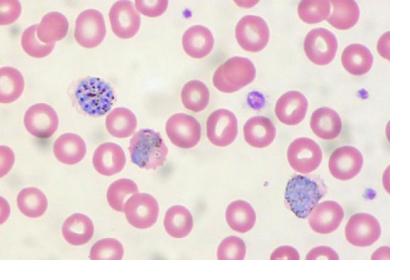
Malaria in peripheral blood.Image: Ed Uthman/Flickr/CC-BY-2.0.

In May 2017, a team of scientists from West Virginia University used satellites to monitor temperatures, water storage, precipitation and land in order to predict a cholera outbreak in Yemen. After processing the satellite data in algorithms, the team was able to come up with a prediction model and ultimately to identify the particular areas that were most at risk for an outbreak several weeks before the event took place. The result of the successful test in Yemen highlights how public health technologies could benefit from the use of satellite data for disease forecasting.
According to the World Health Organization (WHO), cholera affects millions of people each year and it remains, to this day, a major public health risk in certain areas of the world. Due to the short incubation period of the disease, it often happens that communities become aware of an epidemic only after it is already underway. By being able to predict an epidemic and to anticipate the place where it will happen, health workers could prepare in advance by stockpiling rehydration supplies, medicines and vaccines which could ultimately save lives and stop the spreading of the disease.
Collecting ground data about these type of events in a timely manner can prove to be a challenging task since often the regions where such events take place are experiencing civil unrest and political instability which makes it difficult for researchers to collect data. Satellites represent a reliable way of gathering the necessary data remotely.
The team is working with a number of international agencies in order to find the best way to communicate future predictions to the public in a way that will not cause panic. Furthermore, the team is developing a platform that will provide warnings four weeks before an epidemic takes place. The platform uses hydrologic and societal conditions to determine the probability of cholera outbreaks globally.
Such undertakings could, therefore, represent a life-saving tool for the future. In fact, similar satellite-based efforts have been conducted, for example, by the National Oceanic and Atmospheric Administration (NOAA) and the National Aeronautics and Space Administration (NASA). Satellite-based information has been used to predict outbreaks of meningitis, which is more common in dry and dusty conditions, or outbreaks of malaria in Sub-Saharan Africa and the Amazon rainforest.
For example, the Land Data Assimilation System (LDAS) project uses data from the Landsat, and Terra and Aqua satellites as well as from the Global Precipitation Measurement (GPM) mission in order to track environmental factors (e.g. precipitation, soil moisture, air temperature and vegetation) and human activities (e.g. logging) over the Amazon rainforest in South America. Since the Anopheles darlingi mosquito, the host of malaria in the region, may be attracted by rainfall and logging, scientists can use the satellite information to predict the places where loggers are most likely to enter the jungle and therefore catch malaria. The prediction models can subsequently be used by public health officials in order to make better-informed preparations for this type of event and to send aid to people that are most likely to be affected.
According to NASA, countries that have lands inside the Amazon basin (such as Peru, Colombia and Ecuador) have already expressed interest in the LDAS initiative and are expected to be ready to use the malaria prediction tools within the next few years.
The use of space technologies in global health has been addressed under thematic priority 5 of the UNISPACE+50 process, “Strengthening capacity-building in advancing space technologies in global health efforts”. A note prepared by the Expert Group on Space and Global Health of the Scientific and Technical Subcommittee of the Committee on the Peaceful Uses of Outer Space (COPUOS) on thematic priority five can be retrieved online.
Read more: How NASA Satellites Are Helping to Halt Malaria Outbreaks